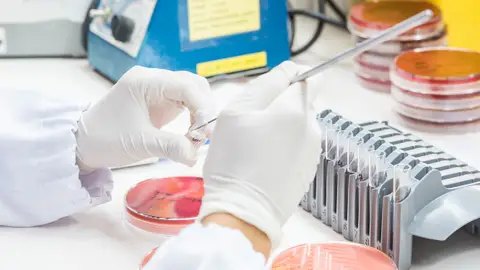

CUIDADOS
La OMS advierte de que la resistencia a los antibióticos ha aumentado en más del 40% en los últimos años
El nuevo informe mundial sobre vigilancia de la resistencia a los antibióticos 2025 presenta, por primera vez, estimaciones de la prevalencia de la resistencia en 22 antibióticos utilizados para tratar infecciones del tracto urinario y gastrointestinal, del torrente sanguíneo y para tratar la gonorrea.
Publicidad
Un nuevo informe de la Organización Mundial de la Salud (OMS) advierte de que el aumento de la resistencia a los antibióticos esenciales representa una creciente amenaza para la salud mundial, ya que, entre 2018 y 2023, creció en más del 40 por ciento de las combinaciones de patógenos y antibióticos supervisadas, con un incremento medio anual del 5 al 15 por ciento.
Además, en 2023, una de cada seis infecciones bacterianas confirmadas en laboratorio y responsables de infecciones comunes en personas de todo el mundo era resistente a los tratamientos con antibióticos. Así lo indican los datos comunicados al Sistema Mundial de Vigilancia de la Resistencia a los Antimicrobianos y su Uso (GLASS, por sus siglas en inglés) de la OMS por más de 100 países.
El nuevo informe mundial sobre vigilancia de la resistencia a los antibióticos 2025 presenta, por primera vez, estimaciones de la prevalencia de la resistencia en 22 antibióticos utilizados para tratar infecciones del tracto urinario y gastrointestinal, del torrente sanguíneo y para tratar la gonorrea.
El informe abarca ocho patógenos bacterianos comunes -Acinetobacter spp., Escherichia coli, Klebsiella pneumoniae, Neisseria gonorrhoeae, Salmonella spp. no tifoidea, Shigella spp., Staphylococcus aureus y Streptococcus pneumoniae-, cada uno de ellos relacionado con una o varias de estas infecciones.
El riesgo de resistencia a los antibióticos varía en todo el mundo
La OMS estima que la resistencia a los antibióticos es mayor en las regiones del Sudeste Asiático y el Mediterráneo Oriental, donde 1 de cada 3 infecciones notificadas era resistente. En la región africana, 1 de cada 5 infecciones era resistente. La resistencia también es más frecuente y está empeorando en lugares donde los sistemas de salud carecen de capacidad para diagnosticar o tratar los patógenos bacterianos.
"La resistencia a los antimicrobianos está superando los avances de la medicina moderna y amenazando la salud de las familias de todo el mundo", ha afirmado Tedros Adhanom Ghebreyesus, director general de la OMS.
"A medida que los países refuerzan sus sistemas de vigilancia de la resistencia a los antimicrobianos, debemos utilizar los antibióticos de forma responsable y garantizar que todo el mundo tenga acceso a los medicamentos adecuados, a diagnósticos de calidad garantizada y a vacunas. Nuestro futuro también depende del fortalecimiento de los sistemas de prevención, diagnóstico y tratamiento de las infecciones, y de la innovación con antibióticos de última generación y pruebas moleculares rápidas en el punto de atención", ha añadido.

Los patógenos bacterianos gramnegativos suponen la mayor amenaza
El nuevo informe señala que las bacterias gramnegativas resistentes a los medicamentos son cada vez más peligrosas en todo el mundo, y que la mayor carga recae sobre los países menos equipados para responder. Entre ellas, E. coli y K. pneumoniae son las principales bacterias gramnegativas resistentes a los medicamentos que se encuentran en las infecciones del torrente sanguíneo.
Se trata de algunas de las infecciones bacterianas más graves, que a menudo provocan sepsis, fallo orgánico y la muerte. Sin embargo, más del 40 por ciento de E. coli y más del 55 por ciento de las cepas de K. pneumoniae en todo el mundo son ahora resistentes a las cefalosporinas de tercera generación, el tratamiento de primera elección para estas infecciones. En la región africana, la resistencia supera incluso el 70 por ciento.
Otros antibióticos esenciales para salvar vidas, como los carbapenémicos y las fluoroquinolonas, están perdiendo eficacia contra E. coli, K. pneumoniae, Salmonella y Acinetobacter. La resistencia a los carbapenémicos, que antes era poco frecuente, es cada vez más habitual, lo que reduce las opciones de tratamiento y obliga a recurrir a antibióticos de último recurso. "Estos antibióticos son costosos, difíciles de conseguir y, a menudo, no están disponibles en los países de ingresos bajos y medios", señala el documento.
Se necesitan más medidas
La OMS indica que la participación de los países en GLASS se ha multiplicado por más de cuatro, pasando de 25 países en 2016 a 104 países en 2023. Sin embargo, la Organización lamenta que el 48 por ciento de los países no comunicaron datos a GLASS en 2023 y aproximadamente la mitad de los países que sí lo hicieron seguían careciendo de sistemas para generar datos fiables. "De hecho, los países que se enfrentan a los mayores retos carecían de la capacidad de vigilancia necesaria para evaluar su situación en materia de resistencia a los antimicrobianos (RAM)", agrega.
La declaración política sobre la RAM adoptada en la Asamblea General de las Naciones Unidas en 2024 estableció objetivos para abordar la RAM mediante el fortalecimiento de los sistemas de salud y el trabajo con un enfoque 'Una sola salud' que coordina los sectores de la salud humana, la salud animal y el medio ambiente. Para combatir el desafío de la RAM, los países deben comprometerse a fortalecer los sistemas de laboratorio y generar datos de vigilancia fiables, especialmente de las zonas desatendidas, para informar los tratamientos y las políticas.
La OMS insta a todos los países a que comuniquen datos de alta calidad sobre la RAM y el uso de antimicrobianos al GLASS para 2030. Para alcanzar este objetivo será necesaria una acción concertada que refuerce la calidad, la cobertura geográfica y el intercambio de datos de vigilancia de la RAM con el fin de realizar un seguimiento de los progresos. Los países deben ampliar las intervenciones coordinadas destinadas a abordar la resistencia a los antimicrobianos en todos los niveles de la atención sanitaria y garantizar que las directrices de tratamiento y las listas de medicamentos esenciales se ajusten a los patrones de resistencia locales.
Publicidad





